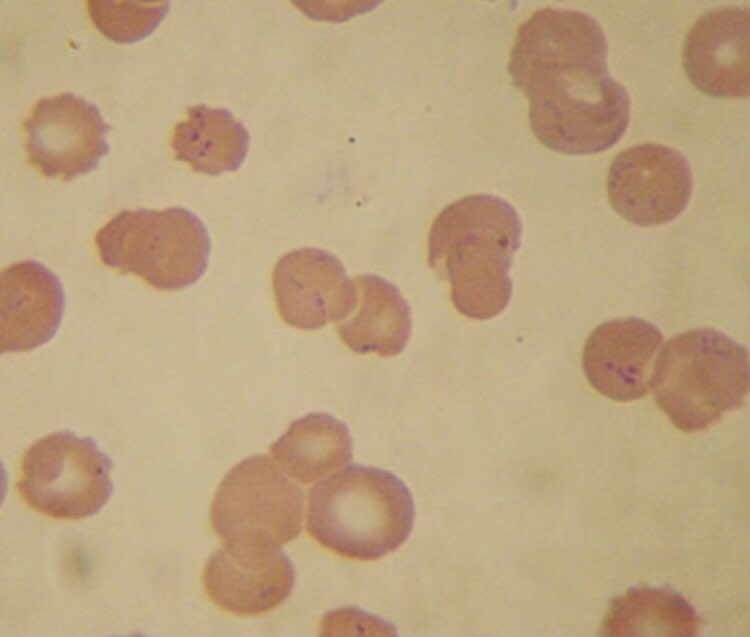
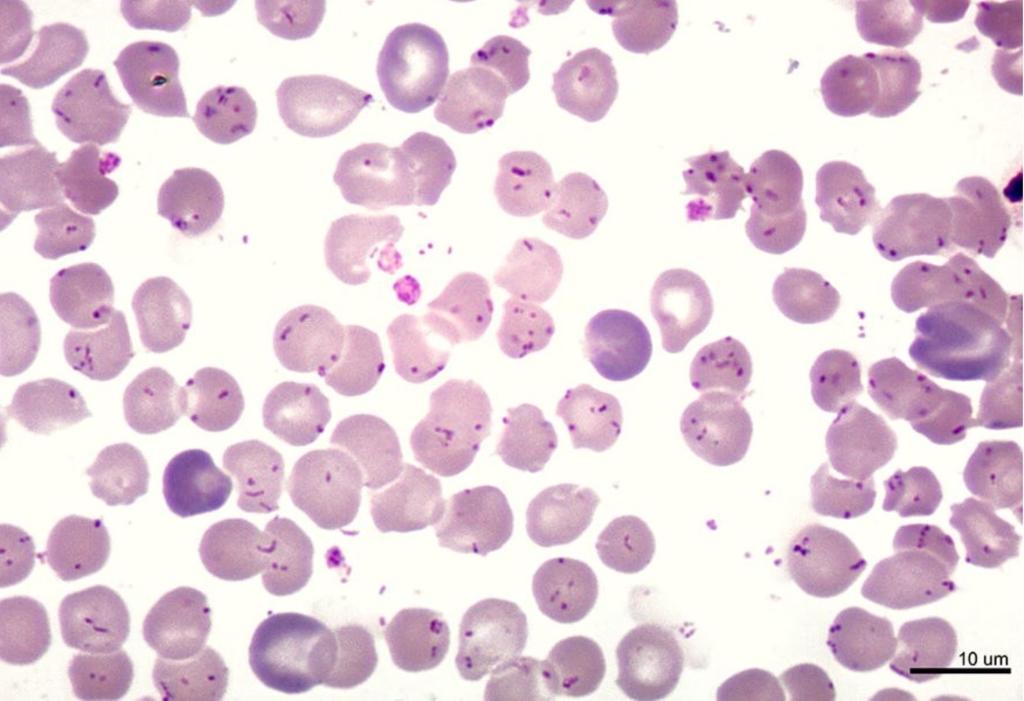

Jaymo
@jaymokorir
ID: 1838303240162537472
23-09-2024 19:43:55
134 Tweet
5 Followers
436 Following

1/Break out your schemas! Let’s talk about a case tweetorial-style courtesy of Daniel Minter . Thanks Tony Goncalves, MedEd Pittsburgh , BCM IM Residency and Robert Centor MD MACP 🇮🇱 @rmcentor.bsky.social and many others for the inspiration. :)